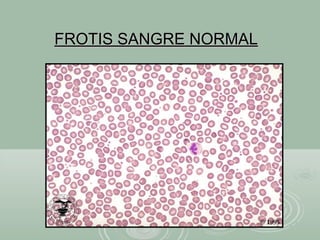
FROTIS SANGRE NORMALFROTIS SANGRE NORMAL
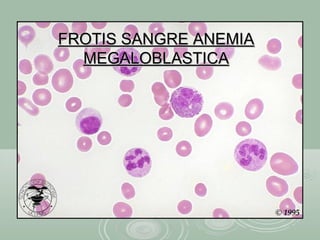
FROTIS SANGRE ANEMIAFROTIS SANGRE ANEMIA
MEGALOBLASTICAMEGALOBLASTICA
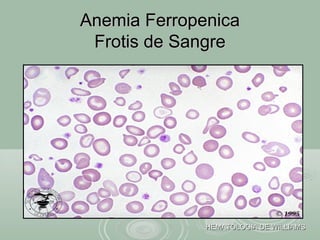
Anemia FerropenicaAnemia Ferropenica
Frotis de SangreFrotis de Sangre
HEMATOLOGIA DE WILLIAMSHEMATOLOGIA DE WILLIAMS

Este documento describe las anemias megaloblásticas. Explica que son trastornos causados por alteraciones en la síntesis de DNA, caracterizados por la presencia de células megaloblásticas en la sangre. Las más comunes son la deficiencia de ácido fólico y la deficiencia de cobalamina. Detalla los síntomas, hallazgos de laboratorio como macrocitosis y células anormales en el frotis, y el tratamiento con suplementos de ácido fólico o cobalamina.